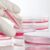

Renal cell carcinoma symptoms causes diagnosis and treatment is a complex topic. Understanding the potential symptoms, underlying causes, and available diagnostic methods and treatment options is crucial for anyone concerned about this type of kidney cancer. From subtle warning signs to advanced diagnostic techniques and personalized treatment plans, this exploration provides a comprehensive overview.
This in-depth look at renal cell carcinoma will cover the various symptoms, ranging from common indicators to those that might be easily overlooked. We will also examine the causes, including genetic predispositions and environmental factors, and delve into the diagnostic process, including imaging and blood tests. Finally, we’ll explore the different treatment approaches, highlighting the potential side effects and the importance of individualized care.
Symptoms
Renal cell carcinoma (RCC), while often silent in its early stages, can manifest with a range of symptoms. Understanding these signs, even subtle ones, is crucial for early detection and treatment. Early diagnosis significantly improves prognosis. Early intervention is critical, as RCC’s early stages are often asymptomatic.Early detection is paramount. A variety of symptoms can arise, some of which are nonspecific, making it challenging to pinpoint the condition.
Recognizing these subtle signs is key to seeking prompt medical attention.
Common Symptoms
The following symptoms are frequently reported by individuals with RCC, and they vary in severity.
- Pain in the side or back: This is a relatively common symptom, often described as a dull ache. The pain may radiate to the abdomen or groin. The pain can be intermittent or persistent.
- Blood in the urine (hematuria): This is a critical symptom. Even small amounts of blood can be detected. The urine might appear pink, red, or brown.
- Lump or mass in the abdomen or flank: While not always present, a palpable mass may be detected, especially in advanced stages. The mass’s size and consistency can vary.
- Fatigue and weakness: These symptoms are often non-specific and can be attributed to various factors. However, persistent fatigue or weakness should be evaluated.
- Unexplained weight loss: Unexplained weight loss can accompany RCC, although it’s not a hallmark symptom and is seen in various conditions.
Less Common, but Important Symptoms
Certain symptoms, though less frequent, are still crucial to recognize. Distinguishing these from other less serious conditions can be challenging.
- Fever: A low-grade fever might occur in some cases. This symptom, however, is not exclusive to RCC.
- Anemia: The body’s production of red blood cells can be affected, leading to anemia. This is a possible indicator, but not a definitive one.
- High blood pressure: Some individuals experience elevated blood pressure, which might not be directly linked to the tumor itself but could be a consequence of the body’s response to the cancer.
- Changes in bowel or bladder habits: Occasional changes in bowel or bladder habits might occur. These are not specific to RCC and could be related to various other issues.
Symptoms Based on Stage
The severity and presence of symptoms can vary based on the stage of the cancer.
- Early stage: Symptoms may be subtle and easily missed. Often, there are no noticeable symptoms in the early stages, which underscores the importance of regular check-ups.
- Late stage: Symptoms become more pronounced as the tumor grows and spreads. This might include significant pain, noticeable masses, and other more severe symptoms.
Comparison of Symptoms: RCC vs. Benign Kidney Conditions
| Symptom | Renal Cell Carcinoma | Benign Kidney Conditions |
|---|---|---|
| Pain | Often dull, persistent | Can vary in intensity, often intermittent |
| Hematuria | Possible, can be microscopic | Less frequent, often macroscopic |
| Mass | Potentially palpable | Rarely palpable |
| Fatigue | Possible | Possible, but often less severe |
Frequency of Symptoms
The following table summarizes the reported frequency of various symptoms in patients with RCC. Note that these are general observations and individual experiences may differ.
| Symptom | Frequency (approximate) |
|---|---|
| Pain in the side or back | 40-60% |
| Hematuria | 20-40% |
| Lump/mass | 10-30% |
| Fatigue | 20-50% |
| Unexplained weight loss | 10-30% |
Causes
Unraveling the mysteries behind renal cell carcinoma (RCC) requires understanding the intricate interplay of genetic predispositions and environmental influences. While a definitive cause is often elusive, numerous factors have been implicated in the development of this aggressive malignancy. This exploration delves into the known risk factors, their mechanisms of action, and the role of specific genetic mutations in increasing the likelihood of RCC.The development of RCC is a complex process, not a single event.
Multiple factors, acting either individually or in concert, contribute to the transformation of healthy kidney cells into cancerous ones. These factors include inherited genetic tendencies, lifestyle choices, and environmental exposures. Understanding these factors is crucial for developing preventative strategies and targeted therapies.
Renal cell carcinoma, a serious kidney cancer, presents with various symptoms like blood in the urine, pain, and fatigue. Understanding its causes, including genetic predisposition and lifestyle factors, is crucial. Diagnosis often involves imaging tests and biopsies. Treatment options range from surgery to targeted therapies, and sometimes involve exploring other conditions like hidradenitis suppurative and covid 19 to rule out confounding factors.
Ultimately, early detection and appropriate treatment are vital for managing this potentially life-threatening disease.
Risk Factors for Renal Cell Carcinoma
Various factors elevate the risk of developing renal cell carcinoma. These include a combination of hereditary predisposition and environmental influences. Recognizing these factors allows for proactive measures to mitigate the risk.
Genetic Predispositions
Certain genetic mutations significantly increase the risk of RCC. These mutations can be inherited from parents or arise spontaneously during a person’s lifetime. Familial cases often highlight the importance of genetic screening and preventative measures.
- Von Hippel-Lindau (VHL) syndrome is an inherited disorder characterized by the presence of multiple tumors in various parts of the body, including the kidneys. Mutations in the VHL gene disrupt the body’s normal tumor-suppressing mechanisms, leading to an increased risk of developing RCC.
- Hereditary leiomyomatosis and renal cell cancer (HLRCC) syndrome involves mutations in the FH gene. These mutations disrupt cell signaling pathways, increasing the risk of RCC.
- Tuberous sclerosis complex (TSC) is another inherited disorder associated with tumors in various organs. Mutations in either TSC1 or TSC2 genes are implicated in the development of RCC.
Environmental Influences
Environmental exposures also play a crucial role in the development of RCC. Certain lifestyle choices and environmental factors can increase the risk.
- Smoking is a well-established risk factor for RCC. The carcinogens in tobacco smoke damage DNA and disrupt cellular processes, increasing the chance of uncontrolled cell growth.
- Obesity is a significant risk factor, and is correlated with increased production of inflammatory cytokines and growth factors that promote tumor development.
- Exposure to certain chemicals and environmental toxins, like asbestos and cadmium, have also been linked to an elevated risk of RCC.
Specific Genetic Mutations
Mutations in specific genes are crucial in the development of RCC. These mutations disrupt cellular processes, promoting uncontrolled cell growth.
- MET gene amplification and mutations are often associated with aggressive forms of RCC. These mutations promote abnormal cell growth and survival.
- PIK3CA mutations are associated with specific RCC subtypes and are often linked to more aggressive behavior.
- BAP1 mutations, found in a subset of RCC cases, can cause significant genomic instability, leading to a higher risk of recurrence and progression.
Subtypes of Renal Cell Carcinoma
Different subtypes of RCC exhibit varying risk factors. While the underlying mechanisms are often similar, specific factors might play a more prominent role in certain subtypes.
- Clear cell RCC (ccRCC) is the most common subtype. Genetic predisposition, such as VHL syndrome, is a key risk factor. Environmental factors, like smoking and obesity, may also contribute.
- Papillary RCC (pRCC) has been associated with environmental exposures, particularly exposure to certain chemicals and toxins. Smoking and obesity have also been associated with increased risk.
Risk Factors Summary
| Risk Factor | Potential Impact | Supporting Evidence |
|---|---|---|
| Genetic Predisposition (e.g., VHL syndrome) | Increased susceptibility to RCC development | Studies demonstrating familial clustering of RCC cases and identified genetic mutations. |
| Smoking | Disruption of cellular processes, DNA damage | Numerous epidemiological studies showing a correlation between smoking and RCC risk. |
| Obesity | Increased inflammation, altered growth factors | Studies linking obesity to increased RCC incidence and aggressive tumor characteristics. |
| Exposure to certain chemicals/toxins | DNA damage, cellular dysfunction | Studies associating specific environmental exposures with RCC risk. |
Diagnosis

Unveiling the presence of renal cell carcinoma (RCC) requires a meticulous approach, moving beyond symptoms and into the realm of definitive testing. This process involves a combination of imaging techniques, blood work, and sometimes, invasive procedures. Accurate diagnosis is crucial for tailoring the most effective treatment plan and improving patient outcomes.
Imaging Techniques
Imaging plays a vital role in diagnosing RCC, allowing doctors to visualize the kidney and surrounding structures. Different imaging modalities offer varying degrees of detail and are often used in combination.
- Computed Tomography (CT) Scan: A CT scan utilizes X-rays to generate cross-sectional images of the kidney. The high resolution of CT scans enables detailed visualization of the kidney and its surroundings, allowing for detection of masses, calcifications, and any signs of spread to nearby lymph nodes or other organs. Contrast agents are often administered to enhance the visibility of structures, highlighting areas of concern.
A key advantage is its accessibility and speed, making it a first-line imaging modality.
- Magnetic Resonance Imaging (MRI): MRI uses powerful magnetic fields and radio waves to create detailed images of the kidney. MRI excels at differentiating between healthy and abnormal tissues, often providing superior soft-tissue contrast compared to CT scans. This is particularly useful in evaluating the extent of the tumor and its relationship to surrounding structures. MRI may be chosen when a more precise assessment of soft tissue is needed, or when a patient cannot undergo CT due to allergies or other contraindications.
Learning about renal cell carcinoma symptoms, causes, diagnosis, and treatment is crucial. While understanding the potential health risks of alcohol is equally important, and factors like the short-term effects of alcohol consumption can affect overall well-being, it’s vital to remember that these effects are separate from the specific dangers of renal cell carcinoma. Ultimately, proper diagnosis and treatment for renal cell carcinoma rely on a comprehensive understanding of the condition’s unique characteristics.
- Ultrasound: Ultrasound utilizes high-frequency sound waves to create images of the kidney. It’s a non-invasive technique that is valuable for initial screening and evaluating the size and shape of the kidney. It’s often used as a first-line imaging method to assess the presence of a mass or abnormalities, and to guide biopsies. The portability and real-time imaging capabilities make ultrasound a convenient tool, especially in detecting superficial masses or fluid collections.
Biopsies, Renal cell carcinoma symptoms causes diagnosis and treatment
In cases where imaging findings suggest RCC, a biopsy may be necessary to confirm the diagnosis and determine the specific type of tumor.
- Kidney Biopsy: A kidney biopsy involves taking a small tissue sample from the kidney for microscopic examination. This procedure is typically guided by imaging techniques, such as ultrasound or CT scans, to precisely target the suspicious area. Pathologists meticulously analyze the tissue sample under a microscope, looking for characteristic features of RCC, including cellular atypia and nuclear pleomorphism.
A biopsy provides definitive confirmation of the diagnosis and helps determine the tumor’s grade and stage.
Blood Tests
Blood tests can be valuable indicators in the diagnostic process.
- Tumor Markers: Certain blood markers, such as CA 19-9, CA 125, and CEA, are sometimes elevated in patients with RCC. However, these markers are not specific to RCC and can be elevated in other conditions. Thus, while they can raise suspicion, they aren’t definitive for diagnosis. They are useful as part of a broader diagnostic approach.
- Complete Blood Count (CBC): A CBC assesses various blood components, including red blood cells, white blood cells, and platelets. Anemia, a common symptom in advanced RCC, can be detected through a CBC. Changes in these blood counts can offer clues about the disease’s severity and the patient’s overall health.
- Kidney Function Tests: Blood tests assessing kidney function (e.g., creatinine, BUN) are essential to evaluate the kidney’s overall health and the potential impact of RCC. Abnormal kidney function values can indicate the extent of kidney damage and the potential need for additional treatment considerations.
Diagnostic Accuracy Comparison
The accuracy and effectiveness of different diagnostic tools vary. CT scans are highly accurate in detecting masses and determining the extent of the disease. MRI provides superior soft tissue contrast for detailed visualization. Ultrasound, while useful for initial screening, may not offer the same level of detail as CT or MRI. Biopsy provides the definitive confirmation, correlating imaging and blood tests.
Diagnostic Tests Summary
| Test | Purpose | Typical Results (RCC) |
|---|---|---|
| CT Scan | Detect masses, extent of disease | Abnormal mass, potentially enlarged lymph nodes |
| MRI | Detailed soft tissue assessment | Distinct tumor characteristics, relationship to surrounding structures |
| Ultrasound | Initial screening, guide biopsies | Presence of mass, abnormal kidney shape |
| Kidney Biopsy | Definitive diagnosis | Characteristic RCC features under microscopy |
| Blood Tests (Tumor Markers) | Suspicion of RCC | Elevated levels, but not definitive |
| Blood Tests (CBC) | Assess overall health | Possible anemia |
| Blood Tests (Kidney Function) | Assess kidney health | Abnormal levels may indicate kidney damage |
Treatment: Renal Cell Carcinoma Symptoms Causes Diagnosis And Treatment
Renal cell carcinoma (RCC) treatment approaches vary significantly depending on the tumor’s stage, grade, and the patient’s overall health. Surgical intervention, radiation therapy, and targeted therapies are common strategies, each with specific benefits and potential drawbacks. Understanding these options allows patients and their healthcare teams to make informed decisions about the best course of action.Surgical removal of the tumor remains a cornerstone of RCC treatment.
The type of surgery, from partial nephrectomy (removing part of the kidney) to radical nephrectomy (removing the entire kidney), is determined by the tumor’s size, location, and stage. Minimally invasive techniques are increasingly used to reduce recovery time and potential complications.
Renal cell carcinoma, a serious kidney cancer, can manifest with various symptoms, from blood in the urine to unexplained weight loss. Understanding the causes, diagnosis, and treatment options is crucial for early intervention. Sometimes, the medications used in treatment can have unexpected effects on the digestive system, like those impacting the stomach. For instance, certain chemotherapy drugs can irritate the stomach lining, potentially leading to nausea and discomfort.
Learning more about the effects of medications on the stomach is helpful in managing potential side effects. This knowledge can be invaluable for patients navigating the complexities of renal cell carcinoma treatment and care.
Surgical Approaches
Surgical interventions are frequently the primary treatment for RCC, especially in early-stage disease. The goal of surgery is to remove the tumor completely while minimizing damage to surrounding healthy tissue. Different surgical approaches are tailored to the specific characteristics of the tumor and the patient’s condition.
- Partial nephrectomy involves the removal of the tumor along with a small portion of surrounding healthy kidney tissue. This procedure is often preferred for smaller tumors located in the periphery of the kidney, as it preserves kidney function. For example, a patient with a small, peripheral tumor might benefit from this procedure to maintain kidney function.
- Radical nephrectomy involves the removal of the entire kidney, along with surrounding tissues, including the adrenal gland. This procedure is generally reserved for larger tumors or those involving the entire kidney, or when other treatments are not feasible. In a case where a tumor is extensive, a radical nephrectomy might be the most effective approach.
Radiation Therapy
Radiation therapy uses high-energy beams to damage cancer cells, thus inhibiting their growth. External beam radiation therapy is commonly used for RCC, especially for tumors that are not amenable to surgery or for cases where surgery has been performed and residual tumor remains.
- External beam radiation therapy delivers radiation from a machine outside the body. This approach is typically used to shrink the tumor size prior to surgery or to treat residual disease after surgery. It’s often used in conjunction with other treatments to optimize outcomes. For instance, radiation therapy may be combined with targeted therapies to improve treatment efficacy.
Targeted Therapies
Targeted therapies directly attack specific molecular targets within cancer cells, hindering their growth and survival. These drugs are often used for advanced or metastatic RCC, where other treatments might not be effective.
- These drugs target specific proteins or pathways crucial for tumor growth. Examples include inhibitors of vascular endothelial growth factor (VEGF), which plays a significant role in tumor blood vessel formation. These therapies can be highly effective in certain cases, as demonstrated by clinical trials showing positive response rates. For instance, a patient with advanced RCC might respond well to targeted therapies if the tumor displays specific molecular characteristics.
Chemotherapy
Chemotherapy uses drugs to kill cancer cells throughout the body. Its role in RCC is typically limited, as it is not as effective as surgery, radiation, or targeted therapies in treating most cases of RCC.
- Chemotherapy may be considered in advanced or metastatic RCC when other treatments have failed. It is usually used in combination with other treatments to enhance effectiveness. For example, a patient with metastatic RCC who does not respond to targeted therapies might be considered for chemotherapy in combination with other treatments.
Treatment Comparison Table
| Treatment | Effectiveness | Side Effects | Cost |
|---|---|---|---|
| Surgery (Partial/Radical) | High, especially for early-stage disease | Pain, bleeding, infection, risk of complications | Moderate to High |
| Radiation Therapy | Moderate to High, especially in combination | Fatigue, skin irritation, nausea | Moderate |
| Targeted Therapies | Variable, often effective in specific cases | Fatigue, nausea, diarrhea, high blood pressure | High |
| Chemotherapy | Limited effectiveness in RCC | Nausea, hair loss, fatigue, anemia | Moderate |
Prognosis and Management

Renal cell carcinoma (RCC) prognosis varies significantly, depending on several factors. While it can be a serious condition, early detection and appropriate treatment significantly improve the chances of a positive outcome. Understanding the influencing factors, the importance of follow-up, and the role of supportive care are crucial for managing the disease effectively.The prognosis for RCC is often tied to the stage of the cancer at diagnosis.
Early-stage RCC, when the cancer is confined to the kidney, typically has a better prognosis than advanced-stage RCC, where the cancer has spread to other parts of the body. The patient’s overall health, including pre-existing conditions, also plays a significant role. Factors like age, general fitness, and the presence of other medical issues can impact how the body responds to treatment and the overall prognosis.
Stage of the Cancer
The stage of the cancer, determined by factors such as the size of the tumor, its location within the kidney, and whether it has spread to other parts of the body, is a critical determinant of prognosis. Early-stage RCC, confined to the kidney, typically has a higher chance of cure with surgery alone. Advanced stages, where the cancer has spread to distant organs, require more aggressive treatment approaches and often have a more complex and potentially less favorable prognosis.
It’s important to note that even advanced-stage RCC can respond positively to treatment, leading to prolonged survival and improved quality of life.
Patient’s Overall Health
A patient’s overall health significantly influences the prognosis. Pre-existing medical conditions can impact the body’s ability to tolerate treatment and the effectiveness of therapies. For example, patients with cardiovascular disease or diabetes may require careful management of these conditions during and after RCC treatment. A patient’s age also plays a role, with younger patients often having a better capacity to withstand the rigors of treatment.
These factors are carefully considered by medical professionals when developing an individualized treatment plan.
Response to Treatment
The patient’s response to treatment directly impacts the prognosis. The effectiveness of surgery, chemotherapy, targeted therapy, or immunotherapy varies from person to person. A positive response, characterized by tumor shrinkage or stabilization, usually indicates a better prognosis. Factors like the type of treatment used and the individual’s genetic profile also influence the treatment response. Monitoring the response to treatment is essential for adjusting strategies and ensuring optimal outcomes.
Follow-up Care and Monitoring
Regular follow-up care and monitoring are vital for patients with RCC. This includes periodic check-ups, imaging studies, and blood tests to detect any recurrence or metastasis. Regular monitoring allows for early intervention if there are any signs of the disease returning. The frequency of follow-up visits is determined based on the stage of the cancer, the patient’s response to treatment, and other individual factors.
Early detection of recurrence is key to maximizing treatment options and improving outcomes.
Supportive Care
Supportive care plays a crucial role in managing the physical and emotional challenges associated with RCC. This includes managing pain, fatigue, nausea, and other side effects of treatment. It also involves addressing the psychological impact of the diagnosis, treatment, and potential long-term effects. Support groups, counseling, and emotional support from loved ones can be invaluable resources for patients and their families.
Long-Term Management Strategies and Potential Complications
Long-term management strategies for RCC focus on preventing recurrence and managing potential complications. These may include regular check-ups, lifestyle modifications, and specific medications to manage potential side effects. Potential complications can range from secondary cancers to cardiovascular problems. A personalized plan, tailored to the individual patient’s needs and circumstances, is crucial for successful long-term management. This includes regular discussions with healthcare professionals to adjust the management plan as needed.
Ultimate Conclusion
In conclusion, navigating the world of renal cell carcinoma requires a deep understanding of its multifaceted nature. From recognizing the potential symptoms to comprehending the diagnostic process and available treatments, this exploration provides a solid foundation for informed discussions and decision-making. Remember, early detection and appropriate treatment are key to improving outcomes, and continuous support and follow-up care are vital for long-term management.
The information presented here should not replace professional medical advice. Always consult with a healthcare provider for personalized guidance.